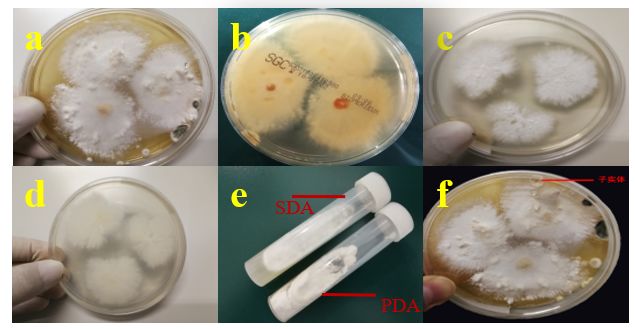

2019-03-06 14:25
作者

1.病情介绍:患者,男性,58岁,电梯工程师。2015年于某大学附属第一医院因右肺上叶后端片状高密度影行右上肺切除术,术后病理显示慢性炎伴脓肿形成及机化,术后恢复良好,无反复咳嗽咳痰等症状。近年体质羸弱,于2018年初无症状服用补肺丸(经淘宝网购买),服用三月后咳嗽、稍活动后即感气喘、胸闷,休息可缓解就诊。自述可咳出粉条样胨状物。胸部CT:“右肺上叶切除术后”改变,右残肺炎症,并右肺上叶部分不张,右肺中叶普遍高密度影,右肺下叶多发小斑片状高密度影,右肺胸膜增厚,高位气管旁及纵膈内多发肿大淋巴结;左肺未见明显异常。电子支气管镜见:右肺上叶残端可见钢针及缝线裸露,表面少许肉芽组织增生,右肺中间段官腔扭曲,右肺中叶官腔可见大量粘性痰栓阻塞官腔,右肺下叶基底段及背段各管口可见痰栓堵塞管口;左肺各级支气管官腔通畅,粘膜光滑,镜下未见新生物。
支气管镜病理:支气管粘膜慢性炎。曾三次经支气管镜从右肺取出大量胨状物,每次支气管镜取完异物后进行肺泡灌洗,肺泡灌洗液呼吸道病原菌核酸检测阴性(肺炎链球菌、金黄色葡萄球菌、大肠埃希菌、肺炎克雷伯菌、铜绿假单胞菌、鲍曼不动杆菌、嗜麦芽窄食单胞菌、流感嗜血杆菌、嗜肺军团菌、肺炎支原体、肺炎衣原体),分枝杆菌核酸检测阴性,GM试验阴性(0.05),G试验阳性(184.9pg/ml);第一次灌洗液送就诊医院真菌培养阴性;后各间隔1周两次取肺泡灌洗液送西京医院检验科做真菌培养。
2.实验室检查
2.1菌落形态:该患者间隔1周两次送检肺泡灌洗液真菌培养,生长较快,3~5d可生长白色绒毛样菌落;在沙保弱培养基(SDA)和马铃薯培养基(PDA)均生长良好,培养5d在沙保弱培养基背面可出现淡黄色,而马铃薯培养基背面不会出现;28℃和35℃均生长良好。15~20d可在培养基见到子实体,见图1。
(图1)a: 5d SDA正面;b: 5d SDA背面;c:5d PDA正面;d: 5d PDA背面;e:5d SDA和PDA培养管;f: SDA,28℃ 18d。
2.2镜下形态:该菌用胶带法和小培养制片,经乳酸棉酚蓝和真菌荧光染色液染色,镜下均可见粗细不一的关节样长菌丝上有钉刺状突起(图2a-b),联合闭锁结构(图2c),不易见到分生孢子,偶见菌丝膨大(图2d)。

(图2)a 乳酸棉酚蓝染色x400倍;b 荧光染色x400倍;c乳酸棉酚蓝染色x1000倍;d 荧光染色x1000倍
白色柱状幼小子实体压片可见菌丝联合闭锁结构,无钉状突起(图3a);较小水母样变异体,外围长条形结构,中心不规则圆形结构(图3b)。黄褐色裂瓣伞样成熟子实体压片可见粗大的菌丝团,无菌丝体制片典型的钉状突起和联合闭锁结构(图3c);较大水母样或者地毯样变异体,外围长条形柱状结构堆积,中心卵圆形为柱状结构顶端截面(图3d)。

(图3)子实体乳酸棉酚蓝染色x400倍。
取子实体做扫描电镜可见菌褶、担子、担孢子及其排列方式,见图4。根据菌落及镜下形态判断为担子菌门的裂褶菌。

(图4)a: ×50菌褶;b: ×1000菌褶;c:×3000担子;d: ×5000担子;e:×5000担孢子;f: ×10000担孢子。
2.3 测序结果:利用真菌通用引物(ITS1:5′-TCCGTAGGTGAAC-CTGCGG-3′;ITS4:5′-GCATCGATGAAGAACGCAGC-3′)扩增真菌核糖体转录间隔区,对PCR产物进行测序,在GenBank中应用blast对获得的基因序列进行同源性分析,发现该株菌与Schizophyllum commune(GenBank NO.MF061788)同源性为100.0%。
2.4 药敏结果:YEAST ONE微量稀释法药敏35℃,96 h可观察结果;FUNG 3微量稀释法药敏35℃,120h可观察结果,两种方法药敏结果一致(MIC值相差≤2个梯度为一致)。体外药敏试验结果如下表:
普通裂褶菌体外药敏结果

3.治疗:该患者经真菌培养为普通裂褶菌,临床诊断为:右上肺切除术后继发真菌感染。
经支气管镜3次各间隔1周时间从肺部取出大量胨状痰栓,每次用大量生理盐水行肺泡灌洗。口服氟康唑200mg/日45天,胸闷、呼吸困难等症状消失。治疗前后CT片见图5。

4.讨论
裂褶菌食、药均可应用,感染人尤其是深部侵袭性感染罕见,为条件致病菌[1-4]。引起感染的轻重程度与机体免疫力密切相关。该菌在室温和35℃均生长良好,具有感染人的基础。
裂褶菌的实验室诊断和实验操作要点:沙保弱培养基和马铃薯培养基均生长良好,生长快,为白色绒毛样菌落;为防止污染可同时接种培养板和培养管,接种培养管螺旋盖不宜拧太紧,或者每日观察时在生物安全柜内拧开再拧紧,以免真菌缺氧。镜下可见粗细不一分隔长菌丝,菌丝上有钉状突起,菌丝分隔处有钳状联合闭锁结构,与文献报道一致[5-6];延长培养时间至15~20d,培养基可见白色短柱状幼小子实体和黄褐色裂瓣伞样成熟子实体,实为罕见。制片采用透明胶带法简单方便,小培养法操作复杂,技术要求高,但镜下结构更典型。典型菌落形态和镜下结构可鉴定到菌属,但需要技术人员有丰富的临床真菌感染学诊断经验和责任心;ITS测序可准确鉴定到种,相比形态学更为方便和准确,需具备相应技术系统。
药敏试验结果显示,两种方法结果相符程度高,相差均在2个梯度内,说明YEAST ONE和FUNG 3微量稀释法均可作为对该菌体外药敏试验的合适方法。氟康唑、5-氟胞嘧啶、卡泊芬净、米卡芬净和阿尼芬净MIC值均≥8 ug/ml,不宜作为该菌治疗药物;两性霉素B、伊曲康唑、伏立康唑和泊沙芬净MIC值均≤1 ug/ml,可根据患者病情、给药方案、毒副作用、经济情况等选择合适的药物治疗。国外文献也有报道,需根据药敏结果选择抗菌药物,经验治疗可选择两性霉素B、伏立康唑和伊曲康唑,后者已有耐药报道[1, 7-10]。9种抗真菌药物对该菌MIC值分散,提示治疗该菌时进行体外药敏试验的必要性。
综上所述,裂褶菌虽为机会致病性真菌,但随着临床各种复杂大型手术、免疫抑制剂的使用、糖皮质激素的使用,以及各种可致免疫力下降的疾病的增多,该菌引起感染的几率亦随之增多[7, 11]。实验室工作人员应牢记该菌的生长特性和形态学特征,并结合DNA测序技术,做到准确诊断,更不能主观判定为环境污染菌而漏诊,不能因对该菌特征不熟悉而误诊。临床治疗应以手术或介入等方法清除菌团,并根据药敏试验MIC值选择合适的抗真菌药物治疗,才能达到有效诊疗。
以便牢记特点,故编打油诗一首,《裂褶菌记》:静寄老林养参菇,忽离枯木害人荼。一袭狐白百媚出,三联闭锁万钉突。
[1] Siqueira J P, Sutton D, Gene J, et al. Schizophyllum radiatum, an Emerging Fungus from Human Respiratory Tract[J]. J Clin Microbiol,2016,54(10):2491-2497.
[2] Verma S, Gupta P, Singh D, et al. Schizophillum commune causing sinusitis with nasal polyposis in the sub-Himalayan region: first case report and review[J]. Mycopathologia,2014,177(1-2):103-110.
[3]Gang GH,Cho HJ,Kim HS,et al. Analysis of fungicide sensitivity and genetic diversity among Colletotrichum species in sweet persimmon[J].Plant Pathol J,2015,31(2): 115-122.
[4] 吴锐浩,陈栎江,徐春泉,等.裂褶菌感染引起变应性支气管肺真菌病1例[J].临床检验杂志,2017,35(10):798-800.
[5] Oliveira M, Lemos A S, Goncalves M, et al. Fungemia associated with Schizophyllum commune in Brazil[J]. PLoS Negl Trop Dis,2017,11(6):e5549.
[6] Liu X, Zou H, Chen Q J, et al. Allergic fungal sinusitis caused by Schizophyllum commune[J]. World J Otorhinolaryngol Head Neck Surg,2017,3(1):59-63.
[7] Toya T, Shinohara A, Tatsuno K, et al. A case of Schizophyllum commune sinusitis following unrelated cord blood transplantation for acute lymphoblastic leukemia[J]. Int J Hematol,2013,98(2):261-263.
[8] 尹秀云,梁钰英,于农, 等.急性白血病患者裂褶菌感染的实验室诊断研究[J].中华医院感染学杂志,2015,25(24):5593-5595.
[9] Tian L, Mu Y, Zhang H, et al. First report on cutaneous infectious granuloma caused by Schizophyllum commune[J]. BMC Infect Dis,2018,18(1):286.
[10] Saha S, Sengupta J, Banerjee D, et al. Schizophyllum commune: a new organism in eye infection[J]. Mycopathologia,2013,175(3-4):357-360.
[11] 尹秀云,梁钰英,于农,等.临床少见丝状真菌的实验室诊断[J].军事医学,2015,39(11):855-858.
[12]马布平,罗祥英,刘书畅,等.裂褶菌研究进展综述[J].食药用菌,2017,25(05):303-307+322.
作者:张鹏亮,白露,徐修礼(空军军医大学西京医院全军临床检验医学研究所微生物室)
审阅:刘颖梅 中日友好医院
王占伟 北京大学人民医院

